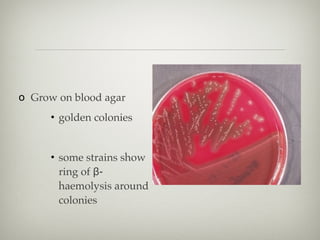
o Grow on blood agar
• golden colonies
• some strains show
ring of β-
haemolysis around
colonies

This document provides information on skin and soft tissue infections (SSTIs). It discusses the difference between uncomplicated and complicated SSTIs, giving examples of each. It also provides short notes on specific SSTIs including impetigo, bullous impetigo, erysipelas, and cellulitis. The document further discusses the typical bacterial causes of various SSTIs and treatment approaches.